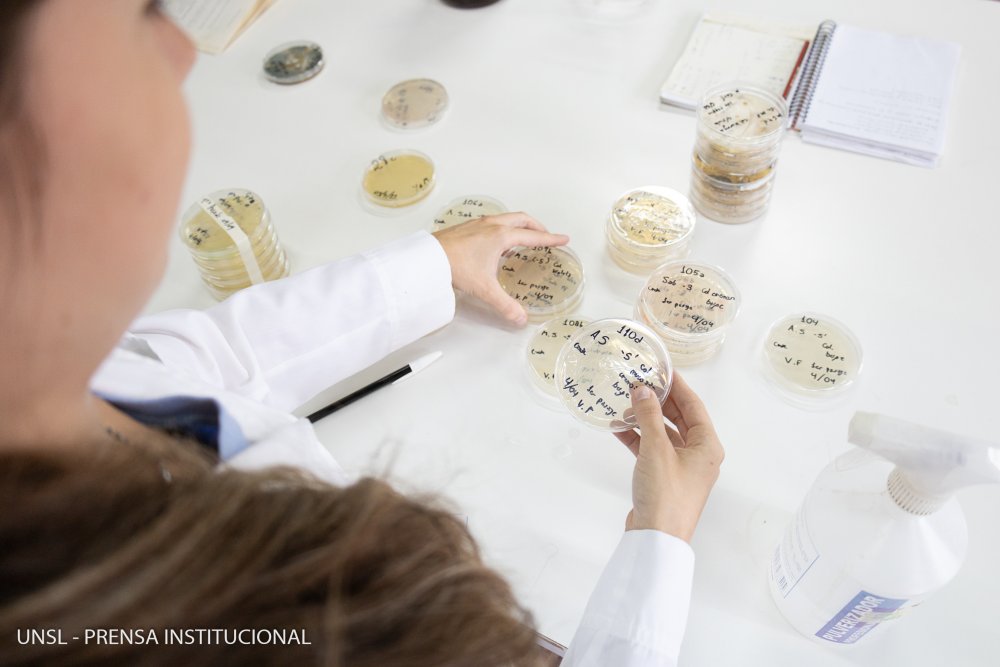

Investigadores del Laboratorio de microbiología Industrial de la Universidad Nacional de San Luis (UNSL) llevan adelante un estudio vinculado a la formulación de levaduras autóctonas para la elaboración de cervezas y la utilización de los desechos que arroja su producción. El proyecto se llama “Desarrollo de Bioinsumos para el sector agropecuario”,.
> Leer también: Tucumán impulsa la investigación local.
Así, en 2017 se creó el Grupo de Investigación, Desarrollo y Asistencia al sector Cervecero (GIDACER), cuyo objetivo es llevar adelante la investigación, la extensión y la vinculación desde la UNSL con los productores, y potenciar una economía circular con valor agregado regional.
Su director, el doctor Gastón Fernández, seńaló a Argentina Investiga que comenzaron a ver que los emprendimientos relacionados con las cervecerías artesanales crecían y que desde el Laboratorio de Microbiología Industrial se contaba con todas las capacidades y los conocimientos de microbiología para trabajar con levaduras. Distintos financiamientos nacionales posibilitaron a los científicos realizar pruebas, tomar experiencia y contactarse con el sector cervecero para ofrecerle servicios.
Dentro de la arista de investigación, los expertos y las expertas trabajan con levaduras no convencionales (que normalmente no son utilizadas para la producción de cerveza) nativas de San Luis y aisladas de las uvas. En la actualidad, se trabaja en un proceso de mejoramiento y domesticación de esa levadura para que aprenda a hacer cerveza, ya que proviene de la uva y su existencia se relaciona con la elaboración del vino. “Esa levadura es natural y la aisló una científica de la UNSL (…) Nosotros vimos que tenía capacidades prometedoras para hacer cerveza. Por ello, la empezamos a estudiar, investigar y enseńar a hacer cerveza”, dijo el especialista.
El científico explicó que esta levadura le aporta características diferenciadas a la cerveza respecto de una levadura industrial y, de esta manera, también le aporta al producto una identidad de origen. “Estamos trabajando en obtener una cerveza hecha con materia prima 100%, producida en San Luis”, agregó.
Economía circular
La producción de cerveza tiene desechos que generan subproductos. Una de las etapas del proceso de elaboración de cerveza es el macerado de la malta. A ese producto se le hace una infusión en agua. De ese proceso, el grano mojado se desecha, y a ese desecho se le llama bagazo. Este material tiene muchas propiedades, nutrientes, carga orgánica y proteínas. Pero también significa una fuente de contaminación para las cervecerías. Los expertos comenzaron a trabajar sobre ese desecho para darle un valor agregado y convertirlo en una materia prima para la producción.
A nivel nacional, los especialistas de la UNSL forman parte de una Red de Seguridad Alimentaria del Conicet, y han trabajado en los últimos tres ańos en que la harina de bagazo sea parte del Código Alimentario Argentino. “La harina existe, se está comercializando pero no hay una normativa (…) Trabajamos en cuál era la normativa para que esa harina cumpliera con las condiciones para que pudiera ser la materia prima para un producto”, indicó el científico.
En la actualidad, el bagazo es un punto fuerte de estudio. A partir de ese material, con desechos de levaduras ya agotadas, se generan medios de cultivo, que es el alimento que necesita el microorganismo para desarrollarse. Ese alimento generalmente es exportado y es costoso. “Queremos abaratar costos a través de la formulación de medios de cultivo a base de bagazo. La persona que consume cerveza artesanal es exigente, pues sabe si esa cerveza cumple con el estilo que dice, si está contaminada o no está contaminada, entonces, muchos cerveceros para generar y mantener esa calidad tratan de armar sus propios laboratorios para hacer controles de calidad tanto del producto terminado, como de la materia prima”, explicó el científico.
Allí los productores y las productoras se encuentran con un cuello de botella, porque los insumos para generar esos laboratorios son elevados, entonces, desde la UNSL se pretende generar medios de cultivo económicos, sencillos y que sean útiles para el productor cervecero. Además de brindar todo el asesoramiento de extensión y de vinculación que esté al alcance.
> Leer también: Llegaron los adoquines anti-smog.
Para analizar estos dos últimos aspectos, los científicos salieron a campo: “Trabajamos y visitamos mucho a las cervecerías y vemos cuáles son sus necesidades. A esas necesidades las traemos al Laboratorio, hacemos una investigación y, después, transferimos los resultados a las cervecerías” concluyó el Fernández.